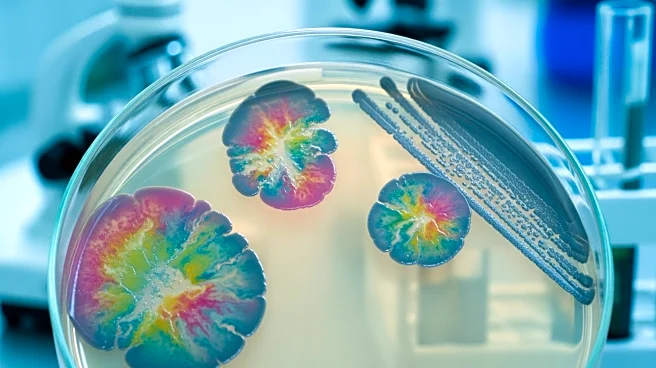
Study Reveals Rising Incidence of Bacteraemia in Norway with Shifts in Microbial Epidemiology

The fight for the No. 1 overall pick in the 2026 NFL Draft this Sunday inside Allegiant Stadium is likely going to be a slugfest in the trenches.
It’ll be the host Las Vegas Raiders’ middling run defense versus the visiting New York Giants’ upper echelon ground game when the two 2-13 football teams square off Sunday. The Silver & Black must be wary of the G-Men’s rushing capabilities because this is the one area where New York is in the Top 10 amongst the 32 NFL teams.
With 2,264 yards gained, the
Giants rank seventh overall in that category. The 415 attempts is third highest while the 19 touchdowns scored is the sixth-highest mark in the league. All this despite losing power back and rookie Cam Skattebo in late October.
And unlike predecessor Brian Daboll (who was not only the Giants head coach but also play caller), interim head honcho Mike Kafka is a run-centric offensive mind.
By The Numbers
New York Giants Rushing
- Leading rusher: RB Tyrone Tracy Jr, 144 carries, 575 yards, 2 touchdowns, 32 first downs
- Most touchdowns: QB Jaxson Dart, 72 carries, 407 yards, 7 touchdowns, 31 first downs
- Don’t forget: RB Devin Singletary, 102 carries, 366 yards, 3 touchdowns, 22 first downs
Expect Patrick Graham’s Raiders run defense to get thoroughly tested. Las Vegas is ranked 16th in terms of yards allowed (1,747) but in the lower ranks when looking at attempts (457, fourth highest) and touchdowns allowed (19, fifth highest).
And with the Giants heading into this Week 17 matchup off a 16-13 loss to the Minnesota Vikings — a game where New York’s offense was limited to 13 passing yards and 128 rushing yards — getting the ground game to align with a productive air attack behind rookie quarterback Jaxson Dart is a must-do for Kafka’s G-Men. That loss last Sunday was Dart’s least productive game in his first year: 7 of 13 for 33 yards, zero touchdowns, one interception; two carries for seven yards, while absorbing five sacks.
But Graham isn’t taking Dart lightly.
“I mean, to start off, funky situation. He had a veteran in front of him, he comes in, dynamic football player. Dynamic football player,” Graham explained. “What I mean by that is explosive plays in the run game. You see it when he creates those plays down there running the ball, explosive plays in terms of pass game, he has arm talent like and then the fact that the loose plays when he gets outside the pocket, can get the ball down the field. He’s doing a good job of distributing the ball.”
Interestingly enough, Daboll’s dismissal and Kafka’s ascension seems to have created quite the diverging path for Dart — as the post below illustrates.
Regardless, Dart has young and productive pass catchers Wan’Dale Robinson (wide receiver, 81 receptions for 901 yards and four touchdowns) and Theo Johnson (tight end, 45 receptions, 528 yards, five touchdowns) to throw to. And he has running backs Tyron Tracy Jr. and Devin Singletary to hand off the ball too along with his own capable legs.
And Graham is treating the 22-year-old signal caller as a capable dual threat.
“And then I always talk about with the quarterbacks, how is he checking in and out of the runs? He’s doing a good job with their check with the run game; you can see that he’s getting some favorable looks for him,” Graham noted of Dart. “But, I mean, it’s a good young player that’s just starting his NFL career, has a level of toughness; he’ll throw it up in there with against anybody. So, I mean, it’s definitely a challenge for us.”
Quote of Note
“I can’t speak for those guys, but I would assume anytime you stay stagnant in this league or get complacent, you’re going to get passed by. It’s a young people league. I mean, that’s what it is. I mean, they draft a whole bunch of guys in April, but they draft a whole bunch of guys to come in here to replace these guys for their jobs. So, if you get complacent, like, and they’re cheaper. So, that’s the nature of the business. So, if you get complacent, you’d better be thinking about the next thing. Take care of the moment, but you’d better be trying to get better than you were the day before. Because, I mean, just the nature of the business, they’re trying to replace you, because the young guys are cheaper and they’re younger.”
—Las Vegas Raiders defensive coordinator Patrick Graham on the “What’s Next” mentality
Head-to-Head
Sunday’s tilt marks the 16th time the Raiders and Giants face off. The Silver & Black lead the all-time series 9-6 (all regular season clashes) and the most recent belonging to Las Vegas — a 30-6 shellacking back in November of 2023. The Raiders recorded eight sacks and two interceptions in that lopsided affair. Before that, New York dropped Las Vegas 23-16 in November of 2021. The longest winning streak in the matchup was a four-game roll by the Raiders from 1992 to 2001.